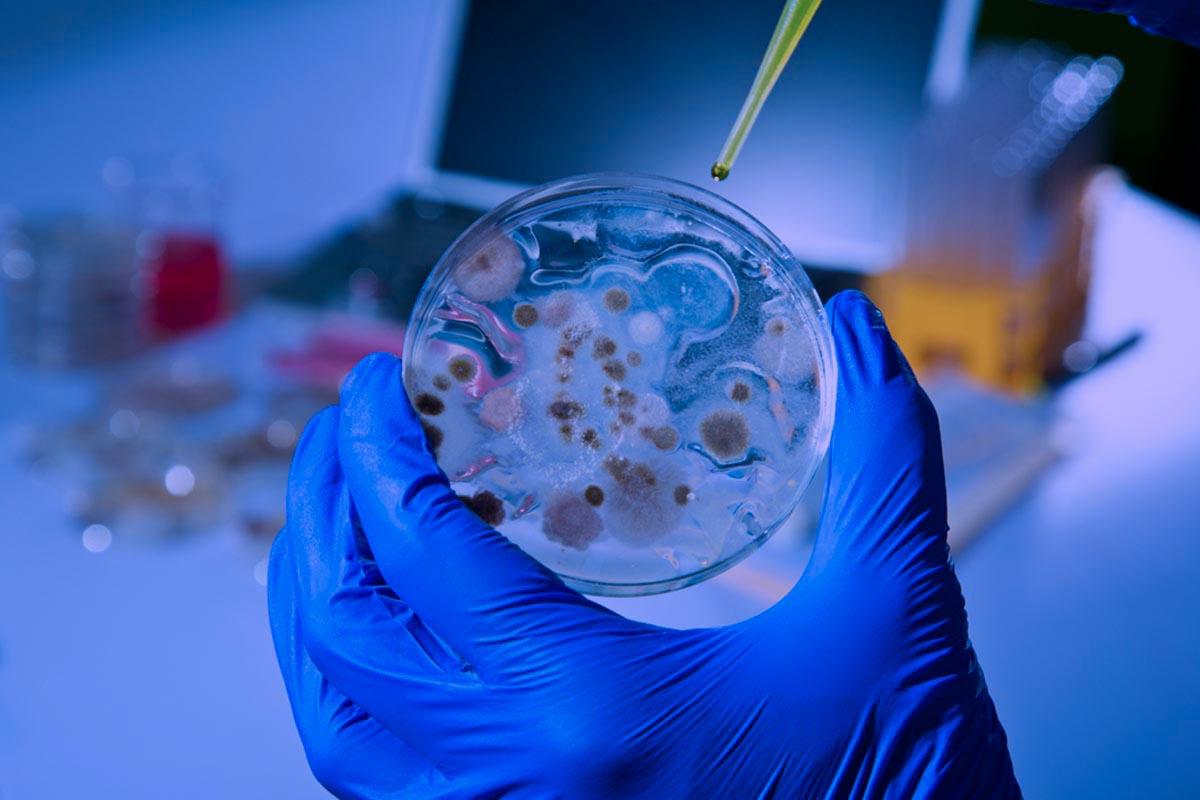

Patrocinados
hEscort.com: La Mejor Plataforma para Encontrar Chicas de Compañía en España

En el mundo de los encuentros exclusivos y el placer de alta categoría, hEscort.com se ha posicionado como la mejor opción para quienes buscan experiencias inolvidables. Con una plataforma moderna, segura y discreta, es el sitio ideal para conectar con chicas de compañía, escorts VIP y putas de lujo en España.
¿Por qué elegir hEscort.com?
Si buscas un servicio premium con la mejor selección de acompañantes en España, estas son algunas de las razones para confiar en hEscort.com:
✅ Perfiles 100% verificados – Garantizamos la autenticidad de cada anuncio para que encuentres exactamente lo que buscas.
✅ Máxima discreción y seguridad – Tu privacidad es nuestra prioridad.
✅ Gran variedad de escorts y servicios – Desde citas románticas hasta experiencias más atrevidas.
✅ Búsqueda avanzada – Encuentra a tu acompañante ideal según ciudad, tipo de servicio y características.
Servicios Exclusivos
En hEscort.com, puedes acceder a diferentes servicios según tus preferencias:
- Chicas de compañía para cenas, eventos y viajes.
- Escorts VIP de alto nivel, con clase y elegancia.
- Putas de lujo expertas en el arte del placer.
- Masajes eróticos para una experiencia de relajación total.
Encuentra Acompañantes en Todo el País
hEscort.com cubre todas las principales ciudades de España, incluyendo Madrid, Barcelona, Valencia, Sevilla y más. Gracias a su sistema intuitivo, podrás filtrar por ubicación y encontrar la mejor compañía cerca de ti.
Descubre el Placer de la Mejor Compañía
Si deseas una experiencia única, exclusiva y sin complicaciones, hEscort.com es la plataforma perfecta para ti. No pierdas la oportunidad de conocer a las mujeres más hermosas y seductoras de España.
👉 Visita hEscort.com y descubre el placer en su máxima expresión.
Categorías
Read More
The Middle East medical devices market size is expected to reach USD 14.37 billion by 2030, registering to grow at a CAGR of 3.9% from 2024 to 2030 according to a new report by Grand View Research, Inc. This growth is anticipated to be a result of increasing geriatric population, and increasing incidences of conventional diseases such as diabetes and obesity. Other major drivers include...

Microbial identification techniques, such as culture-based assays, molecular diagnostics, MALDI-TOF mass spectrometry, and next-generation sequencing, provide rapid, accurate detection of bacteria, fungi, and viruses. These solutions offer streamlined workflows, improved sensitivity, and reduced reagent costs, addressing the increasing demand for timely pathogen identification in clinical...